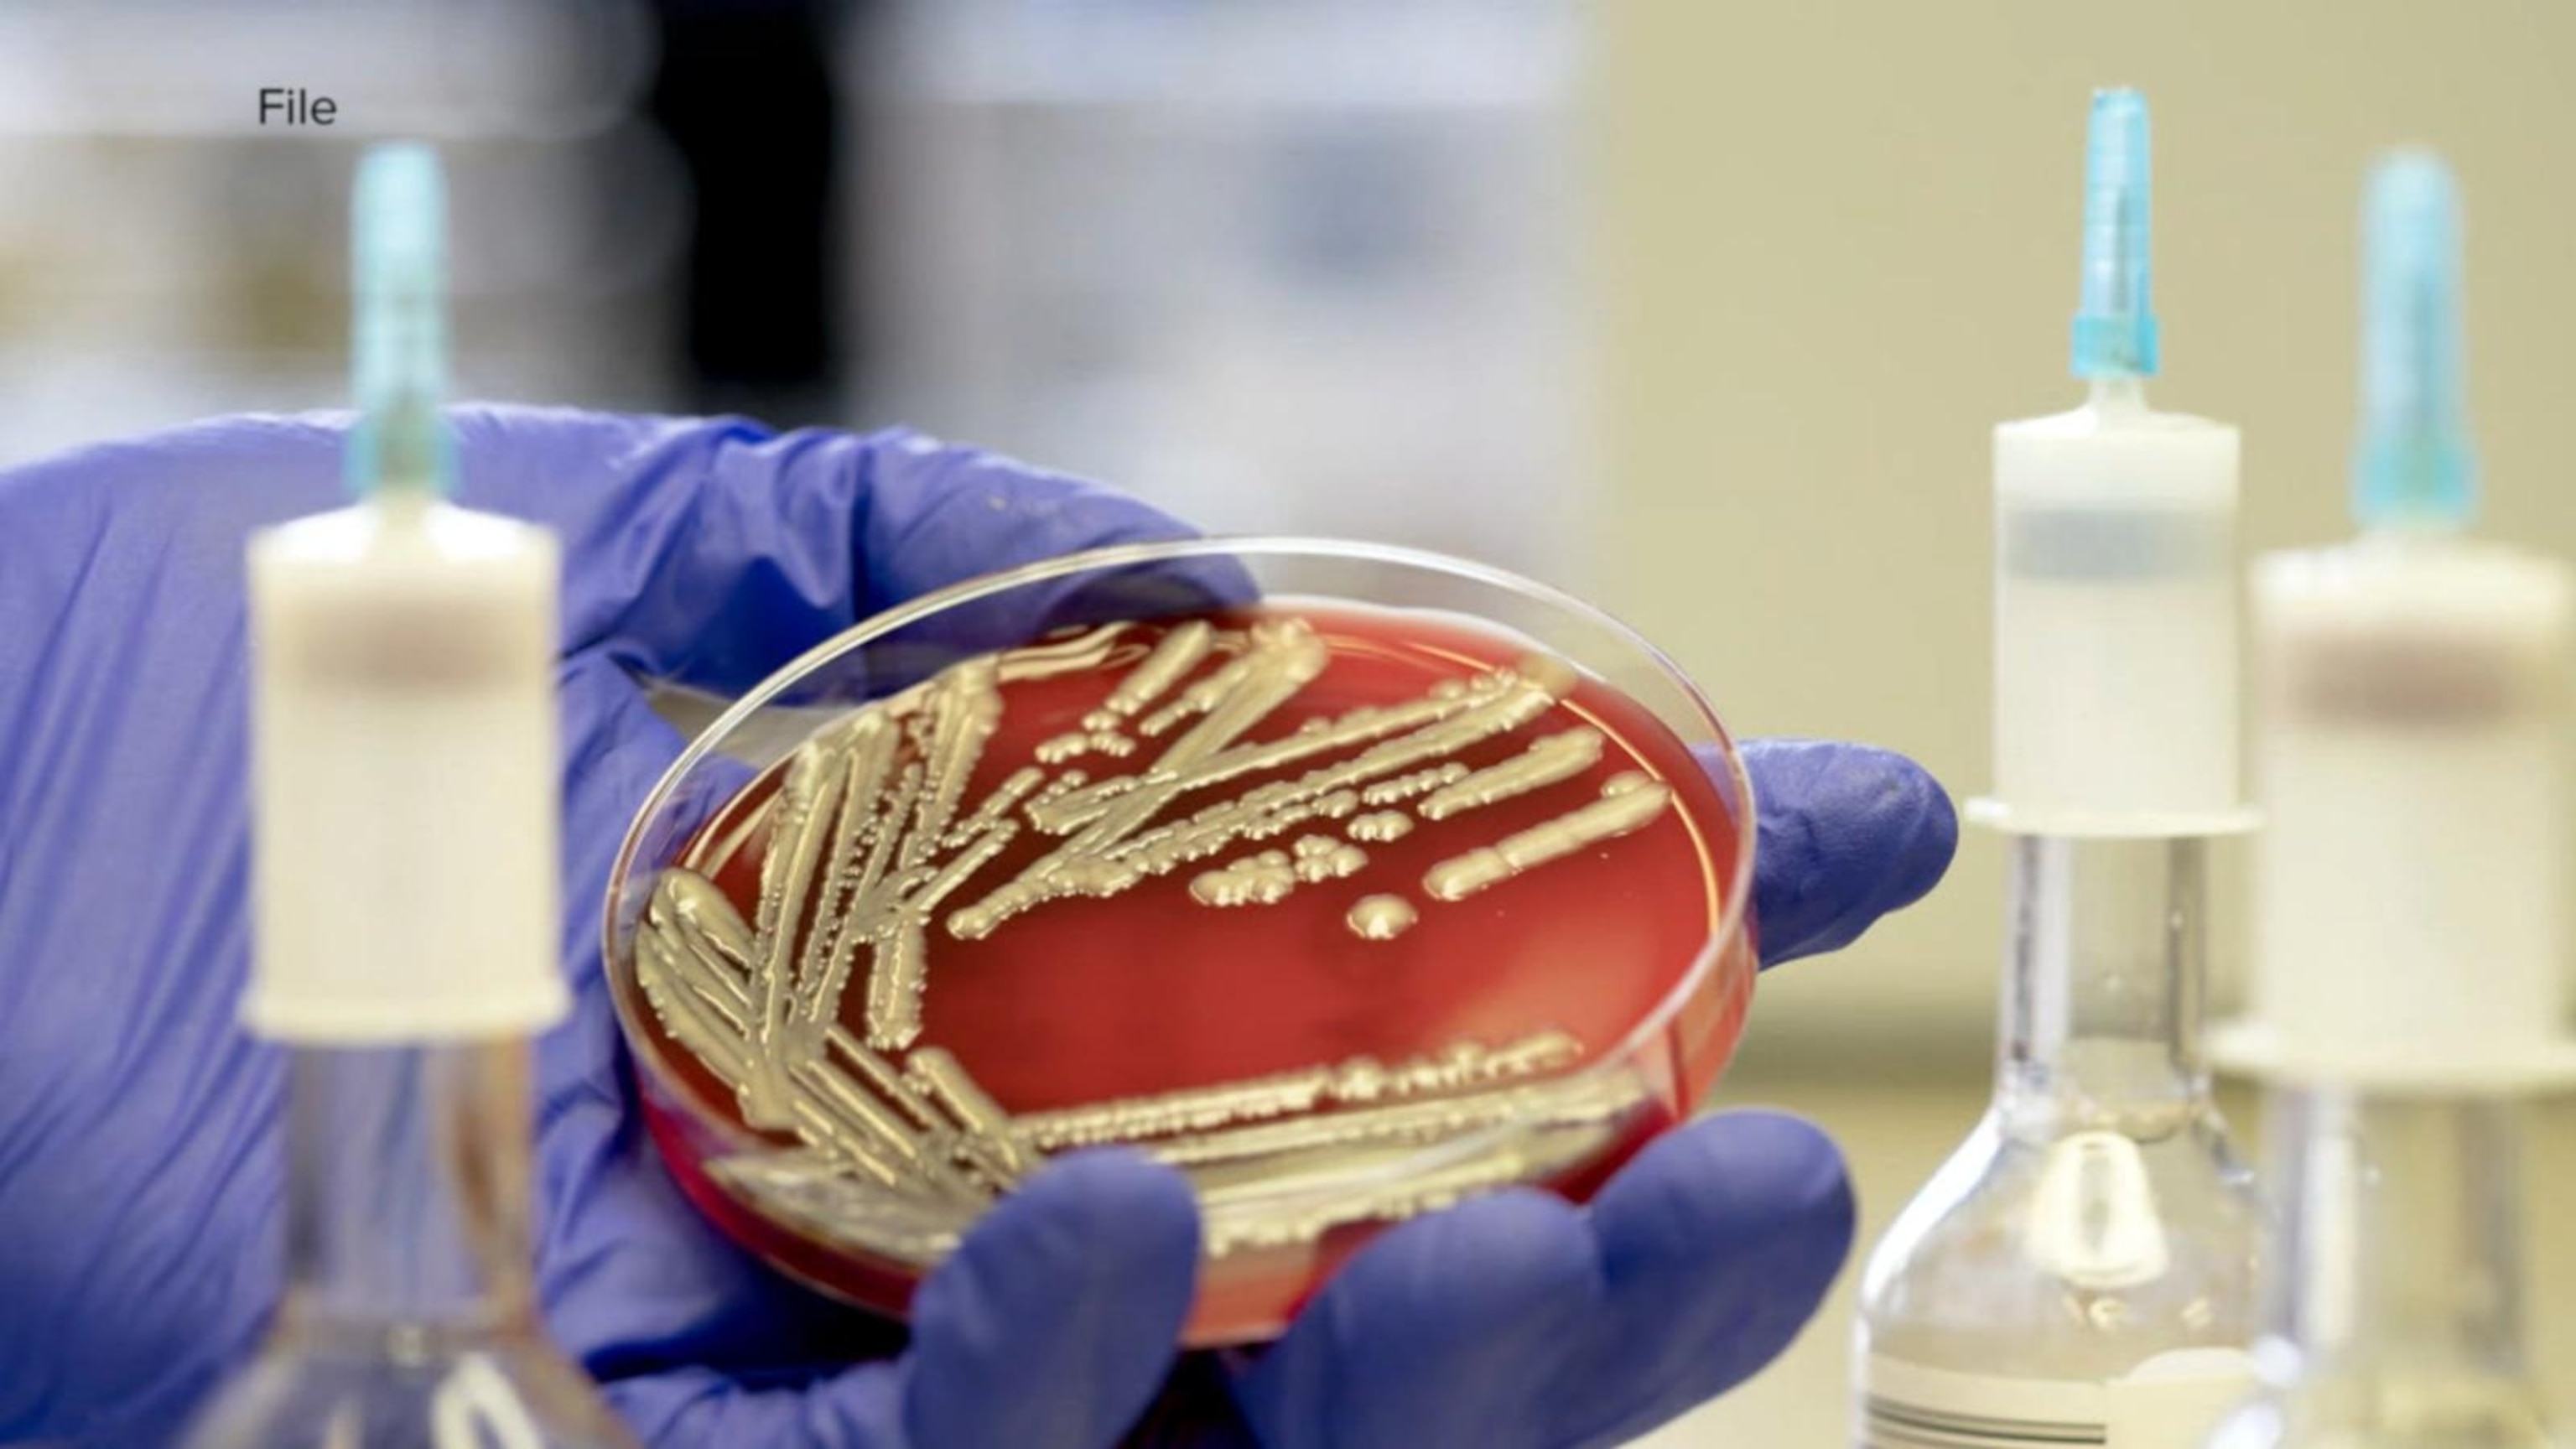

E.coli
Latest Videos

0:16
McDonald's rules out beef patties as the source of deadly E. coli outbreak
- Oct 28, 2024

3:10
Deadly McDonald's E. Coli outbreak sickens at least 75 people in 13 states
- Oct 26, 2024

1:49
McDonald's E. coli outbreak spreads, with at least 74 people sickened
- Oct 25, 2024

1:47
McDonald's says it found source of onions linked E. coli outbreak
- Oct 24, 2024
0:23
E. coli outbreak cases rise
- Aug 25, 2022

2:52
Wendy's serves burgers without lettuce amid E. coli outbreak
- Aug 22, 2022

0:14
Over 42,000-pounds of ground beef recalled
- Jun 15, 2020

0:18
Salad recalled over E. coli fears
- Nov 22, 2019

0:25
Bison meat causes E. coli outbreak: CDC
- Jul 17, 2019

2:16
New E. Coli warning after toddler's death
- Jul 1, 2019
Playlist · 10 Videos








